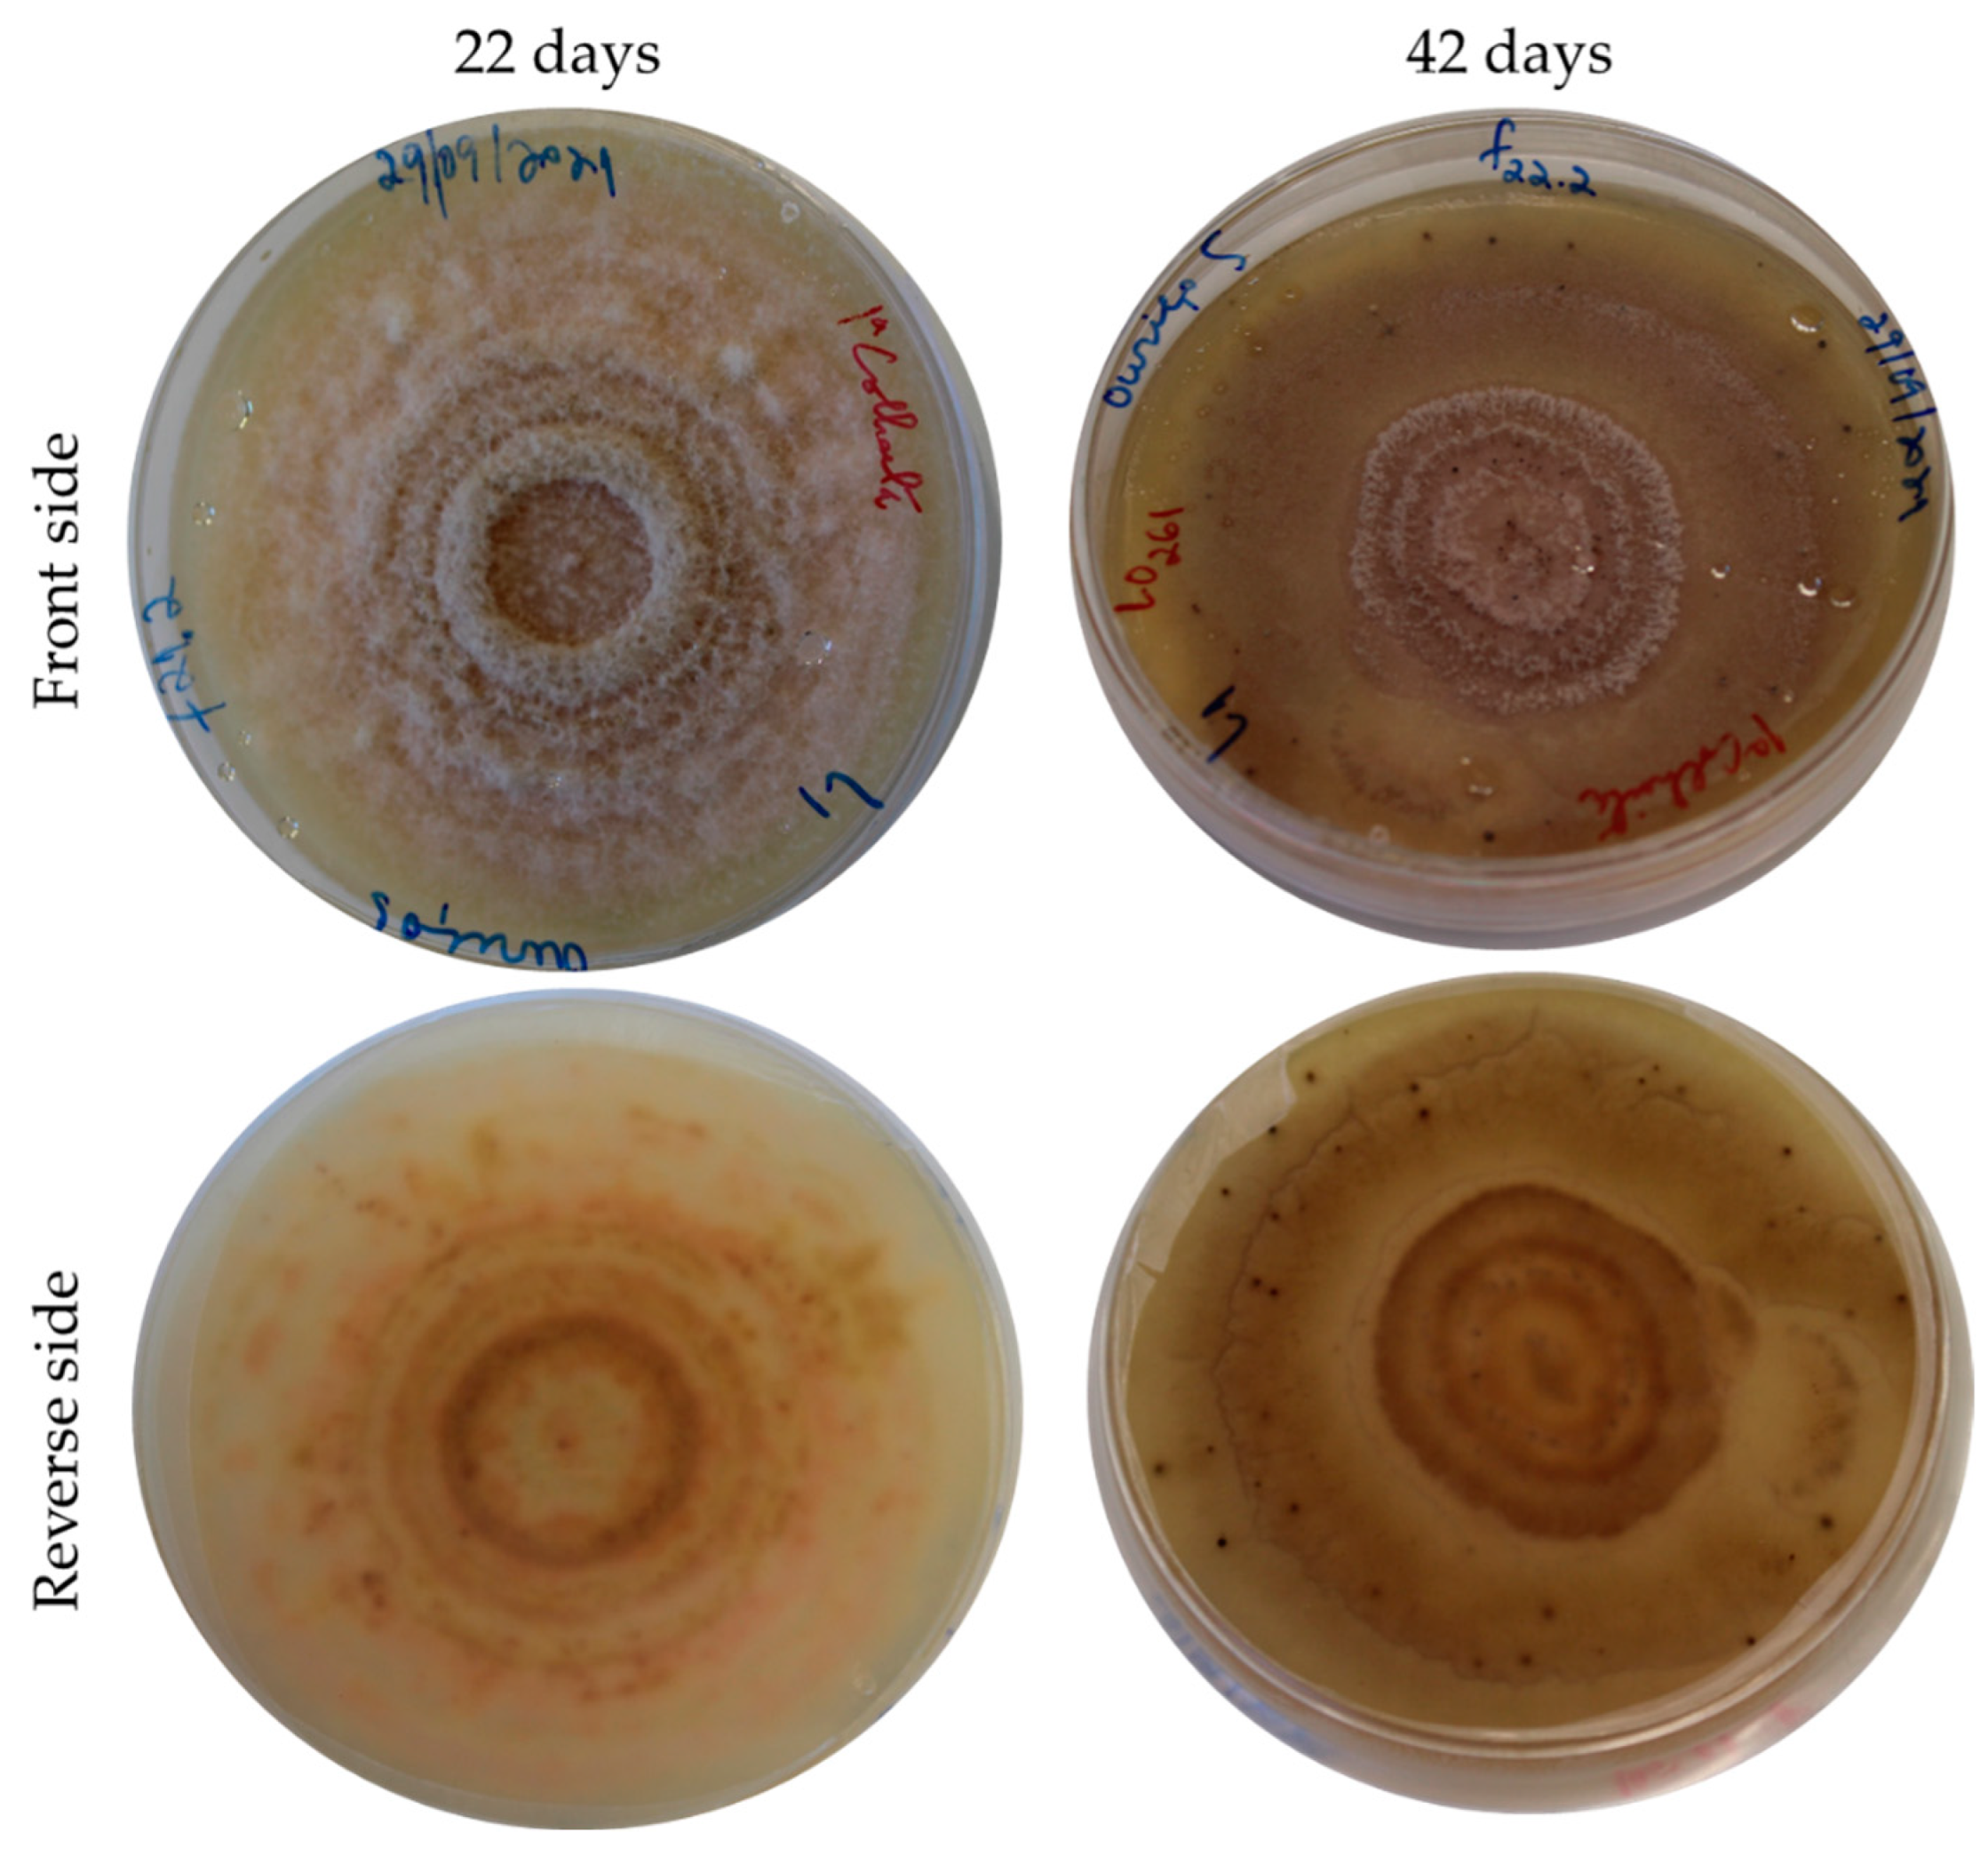
Applsci 13 03969 g002

Brown Rot Caused by Gnomoniopsis smithogilvyi (syn. Gnomoniopsis castaneae) at the Level of the Chestnut Tree (Castanea sativa Mill.)
Featured Application
Abstract
1. Introduction
2. Gnomoniopsis smithogilvyi—Biology, Epidemiology, Symptomatology, and Identification
3. Incidences of the Disease Caused by G. smithogilvyi
4. Damages Caused by G. smithogilvyi
5. Strategies to Mitigate the Damage Caused by Moulds and, in Particular, G. smithogilvyi
6. Future Prospects
- -
- the epidemiology of the disease caused by G. smithogilvyi, particularly the elucidation of the factors that determine the development of the disease. Indeed, it is crucial to understand the role played by biotic (pests, pathogens, etc.) and abiotic (climate change, chestnut grove management, etc.) factors on the transition of the endophyte lifestyle to the active virulent pathogen;
- -
- the geographic distribution and frequency of G. smithogilvyi. The presence of this fungus has already been reported in various regions of the world, but further studies should be carried out in other countries that are important producers of chestnuts, to better know its distribution in the world;
- -
- the relationships of G. smithogilvyi with other fungi, bacteria, cankers, and necrosis of the chestnut tissues. It is essential to find antagonists to this fungus and better understand the metabolic processes that originate cankers and necrosis in leaves and branches. Furthermore, it is necessary to understand the mechanisms that cause the shift from the endophytic to the pathogenic phase;
- -
- the relationship between the wasp D. kuriphilus and G. smithogilvyi, in order to better understand the role played by this insect on the incidence of the disease;
- -
- the identification of methods and/or tools to manage the disease caused by G. smithogilvyi. These may include the identification of C. sativa cultivars that are resistant or at least more tolerant to G. smithogilvyi or improve host plant resistance to the pathogen through breeding programs. This information will be of great interest to producers to help them choose the plant material to use in new plantations as well as to prevent the disease’s development in new plantations. A potential additional measure includes the identification of biocontrol agents, such as micro-organisms, with efficacy against G. smithogilvyi. Furthermore, several cultural practices, such as the removal of fallen burrs (in which the teleomorph stage of the fungus develops) as well as of severely infected plant residues in the field, may all have important implications on the spread of G. smithogilvyi and disease management;
- -
- the identification of the means of spread of the pathogen, either at short or long distances. Indeed, G. smithogilvyi could potentially spread at short distances via natural means (e.g., wind, water splash, and insects) and/or at long distances via human-assisted means (e.g. movement of infected host plants for planting), similarly to other pathogenic fungi;
- -
- the development of methods for the early detection G. smithogilvyi in the groves;
- -
- the elucidation of the mycotoxigenic potential of G. smithogilvyi. This work is extremely important, since its potential is not known;
- -
- the identification of post-harvest management methods for reducing G. smithogilvyi growth, such as the use of disinfectants.
7. Conclusions
Author Contributions
Funding
Institutional Review Board Statement
Informed Consent Statement
Data Availability Statement
Conflicts of Interest
References
- FAOSTAT. Food and Agriculture Organization of the United Nations (FAO). ‘Production of Chestnut by Countries’, Statistics Division. 2020. Available online: https://www.fao.org/faostat/en/#data/QCL (accessed on 21 November 2022).
- Laranjo. Manual Técnico Castanheiro: Estado da Produção; Centro Nacional de Competências dos Frutos Secos: Bragança, Portugal, 2017. [Google Scholar]
- Viva Douro, 2022. Produção de Castanha Martaínha cai 70% em 2022. Newsletter of 18 November 2022. Available online: http://www.public.vivadouro.org/informacao/sociedade/producao-de-castanha-martainha-cai-70-em-2022/#:~:text=Produ%C3%A7%C3%A3o%20de%20castanha%20Marta%C3%ADnha%20cai%2070%25%20em%202022,aponta-se%20para%20uma%20quebra%20de%2070%25%20na%20produ%C3%A7%C3%A3o (accessed on 6 February 2023).
- Ministério da Agricultura. Sub-Fileira: Castanha. Gabinete de Planeamento e Políticas; Castel—Publicações E Edições, Sa: Lisbon, Portugal, 2007; p. 17. [Google Scholar]
- Menu, F.; Debouzie, D. Larval development variation and adult emergence in the chestnut weevil Curculio elephas Gyllenhal (Col., Curculionidae). J. Appl. Entomol. 1995, 119, 279–284. [Google Scholar] [CrossRef]
- Yaman, M.; Demirbag, Z.; Beldüz, A.O. Investigations on the bacterial flora as a potential biocontrol agent of chestnut weevil, Curculio elephas (Coleoptera: Curculionidae) in Turkey. Biologia 1999, 54, 677–681. [Google Scholar]
- Desouhant, E. Selection of fruits for oviposition by the chestnut weevil, Curculio elephas. Entomol. Exp. Et Appl. 1998, 86, 71–78. [Google Scholar] [CrossRef]
- Caliskan, S.; Göltaş, M.; Aslan, V.; Özer, G.; Tandoğan, M.; Sezgin, G.; Cebeci, H. Variation in fruit traits and infestation ratios in natural sweet chestnut (Castanea sativa) populations under chestnut weevil (Curculio elephas) damage. Biologia 2020, 75, 2287–2294. [Google Scholar] [CrossRef]
- Cuestas, M.I.; Martin, M.A.; Aldebis, H.K.; Mena, J.D.; Martin, L.M.; Vargas-Osuna, E. Differential response among chestnut traditional varieties to the attack of Cydia splendana. Neth. Entomol. Soc. Entomol. Exp. Et Appl. 2020, 168, 259–265. [Google Scholar] [CrossRef]
- Ferracini, C.; Pogolotti, C.; Rama, F.; Lentini, G.; Saitta, V.; Mereghetti, P.; Mancardi, P.; Alma, A. Pheromone-Mediated Mating Disruption as Management Option for Cydia spp. in Chestnut Orchard. Insects 2021, 12, 905. [Google Scholar] [CrossRef]
- Jósvai, J.K.; Voigt, E.; Tóth, M. A pear ester-based female-targeted synthetic lure for the chestnut tortrix, Cydia splendana. Entomol. Exp. Et Appl. 2016, 159, 370–374. [Google Scholar] [CrossRef]
- Karagoz, M.; Gulcub, B.; Hazirb, S.; Kaya, H.K. Laboratory evaluation of Turkish entomopathogenic nematodes forsuppression of the chestnut pests, Curculio elephas (Coleoptera: Curculionidae) and Cydia splendana (Lepidoptera: Tortricidae). Biocontrol Sci. Technol. 2009, 19, 755–768. [Google Scholar] [CrossRef]
- Kolp, M.; Fulbright, D.W.; Jarosz, A.M. Inhibition of virulent and hypovirulent Cryphonectria parasitica growth in dual culture by fungi commonly isolated from chestnut blight cankers. Fungal Biol. 2018, 122, 935–942. [Google Scholar] [CrossRef]
- Ježić, M.; Kolp, M.; Prospero, S.; Karin-Kujundžić, V.; Idžojtić, M.; Sotirovski, K.; Risteski, M.; Rigling, D.; Double, M.L.; Ćurković-Perica, M. Diversity of parasitica in callused chestnut blight cankers on European and American chestnut. For. Pathol. 2019, 49, e12566. [Google Scholar] [CrossRef]
- Camisón, Á.; Martín, M.Á.; Sánchez-Bel, P.; Flors, V.; Alcaide, F.; Morcuende, D.; Pinto, G.; Solla, A. Hormone and secondary metabolite profiling in chestnut during susceptible and resistant interactions with Phytophthora cinnamomi. J. Plant Physiol. 2019, 241, 153030. [Google Scholar] [CrossRef] [PubMed]
- Zhebentyayeva, T.N.; Sisco, P.H.; Georgi, L.L.; Jeffers, S.N.; Perkins, M.T.; James, J.B.; Hebard, F.V.; Saski, C.; Nelson, C.D.; Abbott, A.G. Dissecting Resistance to Phytophthora cinnamomi in Interspecific Hybrid Chestnut Crosses Using Sequence-Based Genotyping and QTL Mapping. Phytopathology 2019, 109, 1594–1604. [Google Scholar] [CrossRef] [PubMed]
- INE. Estatísticas Agrícolas 2020; Instituto Nacional de Estatística: Lisbon, Portugal, 2020; ISSN 0079-4139. [Google Scholar]
- Dobry, E.; Campbell, M. Gnomoniopsis castaneae: An emerging plant pathogen and global threat to chestnut systems. Plant Pathol. 2023, 72, 218–231. [Google Scholar] [CrossRef]
- Possamai, G. Podridão da Castanha em Trás-os-Montes: Caracterização Morfológica, Ecofisiológica e Molecular do Agente Causal Gnomoniopsis smithogilvyi. Master’s Thesis, Biotechnological Engineering, Instituto Politécnico de Bragança, Lisbon, Portugal, 2020; p. 85. Available online: https://bibliotecadigital.ipb.pt/bitstream/10198/23171/4/Possamai_Guilherme_Podrida%cc%83o_da_Castanha_em_Tra%cc%81s_os_Montes.pdf (accessed on 20 March 2022).
- Coelho, V.; Gouveia, E. Gnomoniopsis smithogilvyi, the causal agent of chestnut brown rot reported from Portugal. New Dis. Rep. 2021, 43, e12007. [Google Scholar] [CrossRef]
- Visentin, I.; Gentile, S.; Valentino, D.; Gonthier, P.; Tamietti, G.; Cardinale, F. Gnomoniopsis castanea sp. nov. (Gnomoniaceae, Diapothales) as the causal agent of nut rot in sweet chestnut. J. Plant Pathol. 2012, 94, 411–419. [Google Scholar]
- Lione, G.; Danti, R.; Fernandez-Conradi, P.; Ferreira-Cardoso, J.V.; Lefort, F.; Marques, G.; Meyer, J.B.; Prospero, S.; Radócz, L.; Robin, C.; et al. The emerging pathogen of chestnut Gnomoniopsis castaneae: The challenge posed by a versatile fungus. Eur. J. Plant Pathol. 2019, 153, 671–685. [Google Scholar] [CrossRef]
- Cisterna-Oyarce, V.; Carrasco-Fernandez, J.; Castro, J.F.; Santelices, C.; Munoz-Reyes, V.; Millas, P.; Alan, G.; Buddie, A.G.; France, A. Gnomoniopsis smithogilvyi: Identification, characterisation and incidence of the main pathogen causing brown rot in postharvest sweet chestnut fruits (Castanea sativa) in Chile. Australas. Plant Dis. Notes 2022, 17, 3. [Google Scholar] [CrossRef]
- Fernandez-Conradi, P. Diversité des Arbres et Résistance des Forêts Aux Invasions Biologiques: Application au Châtaignier et Son Complexe de Bioagresseurs Exotiques, Chancre (Cryphonectria parasitica) et Cynips (Dryocosmus kuriphilus). Interactions Entre Organismes. Ph.D. Thesis, Université de Bordeaux, Bordeaux, France, 2017. [Google Scholar]
- Fernandez-Conradi, P.; Borowiec, N.; Capdevielle, X.; Castagneyrol, B.; Maltoni, A.; Robin, C.; Selvi, F.; Halder, I.V.; Ve´tillard, F.; Jactel, H. Plant neighbour identity and invasive pathogen infection affect associational resistance to an invasive gall wasp. Biol. Invasions 2017, 20, 1459–1473. [Google Scholar] [CrossRef]
- Dar, M.A.; Rai, M.K. Gnomoniopsis smithogilvyi a canker causing pathogen on Castanea sativa: First report. Mycosphere 2015, 6, 327–336. [Google Scholar] [CrossRef]
- Lewis, A.; Gorton, C.; Rees, H.; Webber, J.; Pérez-Sierra, A. First report of Gnomoniopsis smithogilvyi causing lesions and cankers of sweet chestnut in the United Kingdom. New Dis. Rep. 2017, 35, 20. [Google Scholar] [CrossRef]
- Trapiello, E.; Feito, I.; González, A.J. First report of Gnomoniopsis castaneae causing canker on hybrid plants of Castanea sativa x C. crenata in Spain. Plant Dis. 2017, 102, 1040. [Google Scholar] [CrossRef]
- O´Loinsigh, B.; McAuley, D.; Bréchon, A.L.; Lopez Vernaza, M.; Ryan, C.; Destefanis, M.L.; O’Hanlon, R. First report of the fungus Gnomoniopsis smithogilvyi causing cankers on sweet chestnut (Castanea sativa) in Ireland. New Dis. Rep. 2022, 45, e12072. [Google Scholar] [CrossRef]
- Aglietti, C.; Cappelli, A.; Andreani, A. From Chestnut Tree (Castanea sativa) to Flour and Foods: A Systematic Review of the Main Criticalities and Control Strategies towards the Relaunch of Chestnut Production Chain. Sustainability 2022, 14, 12181. [Google Scholar] [CrossRef]
- Pasche, S.; Calmin, G.; Auderset, G.; Crovadore, J.; Pelleteret, P.; Mauch-Mani, B.; Barja, F.; Paul, B.; Jermini, M.; Lefort, F. Gnomoniopsis smithogilvyi causes chestnut canker symptoms in Castanea sativa shoots in Switzerland. Fungal Genet. Biol. 2016, 87, 9–21. [Google Scholar] [CrossRef] [PubMed]
- EPPO—European and Mediterranean Plant Protection Organization (2017). EPPO Reporting Service No. 02–2017 Num. Article: 2017/047. Available online: http://archives.eppo.int/EPPOReporting/2017/Rse-1702.pdf (accessed on 25 February 2022).
- Shuttleworth, L.A.; Liew, E.C.Y.; Guest, D.I. Fungal Planet Description Sheet 108: Gnomoniopsis smithogilvyi. Persoonia 2012, 28, 142–143. Available online: http://www.fungalplanet.org/content/pdf-files/FungalPlanet108.pdf (accessed on 25 February 2022).
- Shuttleworth, L.A.; Walker, D.M.; Guest, D.I. The chestnut pathogen Gnomoniopsis smithogilvyi (Gnomoniaceae, Diaporthales) and its synonyms. Mycotaxon 2015, 130, 929–940. [Google Scholar] [CrossRef]
- Shuttleworth, L.A.; Guest, D.I.; Walker, D.M. The fungus the Code and the mysterious publication date: Why Gnomoniopsis smithogilvyi is still the correct name for the chestnut rot fungus. IMA Fungus 2018, 9, A78–A79. [Google Scholar] [CrossRef]
- Sillo, F.; Giordano, L.; Zampieri, E.; Lione, G.; De Cesare, S.; Gonthier, P. HRM analysis provides insights on the reproduction mode and the population structure of Gnomoniopsis castaneae in Europe. Plant Pathol. 2017, 66, 293–303. [Google Scholar] [CrossRef]
- Shuttleworth, L.A.; Guest, D.I. The infection process of chestnut rot, an important disease caused by Gnomoniopsis smithogilvyi (Gnomoniaceae, Diaporthales) in Oceania and Europe. Aust. Plant Pathol. 2017, 46, 397–405. [Google Scholar] [CrossRef]
- Lione, G.; Giordano, L.; Sillo, F.; Gonthier, P. Testing and modelling the effects of climate on the incidence of the emergent nut rot agent of chestnut Gnomoniopsis castanea. Plant Pathol. 2015, 64, 852–863. [Google Scholar] [CrossRef]
- Lione, G.; Giordano, L.; Sillo, F.; Brescia, F.; Gonthier, P. Temporal and spatial propagule deposition patterns of the emerging fungal pathogen of chestnut Gnomoniopsis castaneae in orchards of north-western Italy. Plant Pathol. 2021, 70, 2016–2033. [Google Scholar] [CrossRef]
- Arunrat, N.; Sereenonchai, S.; Chaowiwat, W.; Wang, C. Climate change impact on major crop yield and water footprint under CMIP6 climate projections in repeated drought and flood areas in Thailand. Sci. Total Environ. 2022, 807, 150741. [Google Scholar] [CrossRef]
- Gullino, M.L.; Albajes, R.; Al-Jboory, I.; Francislene Angelotti, F.; Chakraborty, S.; Garrett, K.A.; Hurley, B.P.; Juroszek, P.; Lopian, R.; Makkouk, K.; et al. Climate Change and Pathways Used by Pests as Challenges to Plant Health in Agriculture and Forestry. Sustainability 2022, 14, 12421. [Google Scholar] [CrossRef]
- Maresi, G.; Oliveira-Longa, C.M.; Turchetti, T. Brown rot on nuts of Castanea sativa Mill: An emerging disease and its causal agent. Iforest—Biogeosciences For. 2013, 6, 294–301. [Google Scholar] [CrossRef]
- Vannini, A.; Vettraino, A.M.; Martignoni, D.; Morales-Rodriguez, C.; Contarini, M.; Caccia, R.; Paparatti, B.; Speranza, S. Does Gnomoniopsis castanea contribute to the natural biological control of chestnut gall wasp? Fungal Biol. 2017, 121, 44–52. [Google Scholar] [CrossRef] [PubMed]
- Lione, G.; Giordano, L.; Ferracini, C.; Alma, A.; Gonthier, P. Testing ecological interactions between Gnomoniopsis castaneae and Dryocosmus kuriphilus. Acta Oecologica 2016, 77, 10–17. [Google Scholar] [CrossRef]
- Turco, S.; Bastianelli, G.; Morales-Rodrìguez, C.; Vannini, A.; Mazzaglia, A. Development of a TaqMan qPCR assay for the detection and quantification of Gnomoniopsis castaneae in chestnut tissues. For. Pathol. 2021, 51, e12701. [Google Scholar] [CrossRef]
- Aguín, O.; Rial, C.; Piñón, P.; Sainz, M.J.; Mansilla, J.P.; Salinero, C. First Report of Gnomoniopsis smithogilvyi Causing Chestnut Brown Rot on Nuts and Burrs of Sweet Chestnut in Spain. Plant Dis. 2023, 107, 218. [Google Scholar] [CrossRef]
- Dennert, F.G.; Broggini, G.A.L.; Gessler, C.; Storari, M. Gnomoniopsis castanea is the main agent of chestnut nut rot in Switzerland. Phytopathol. Mediterr. 2015, 54, 199–211. [Google Scholar] [CrossRef]
- Meyer, J.B.; Trapiello, E.; Senn-Irlet, B.; Sieber, T.N.; Cornejo, C.; Aghayeva, D.; González, A.J.; Prospero, S. Phylogenetic and phenotypic characterisation of Sirococcus castaneae comb. nov. (synonym Diplodina castaneae), a fungal endophyte of European chestnut. Fungal Biol. 2017, 121, 625–637. [Google Scholar] [CrossRef]
- Silva-Campos, M.; Nadiminti, P.; Cahill, D. Rapid and Accurate Detection of Gnomoniopsis smithogilvyi the Causal Agent of Chestnut Rot, through an Internally Controlled Multiplex PCR Assay. Pathogens 2022, 11, 907. [Google Scholar] [CrossRef] [PubMed]
- Vettraino, A.M.; Luchi, N.; Rizzo, D.; Pepori, A.L.; Pecori, F.; Santini, A. Rapid diagnostics for Gnomoniopsis smithogilvyi (syn. Gnomoniopsis castaneae) Chestnut Nuts: New Chall. By Using LAMP Real-Time PCR Methods. AMB Express 2021, 11, 105. [Google Scholar] [CrossRef]
- White, T.J.; Bruns, S.; Lee, S.; Taylor, J. Amplification and direct sequencing of fungal ribosomal RNA genes for phylogenetics. PCR Protoc. A Guide Methods Appl. 1990, 18, 315–322. [Google Scholar] [CrossRef]
- Sakalidis, M.L.; Medina-Mora, C.M.; Kolp, M.; Fulbright, D.W. First report of Gnomoniopsis smithogilvyi causing chestnut brown rot on chestnut fruit in Michigan. Plant Dis. 2019, 103, 2134. [Google Scholar] [CrossRef]
- Smith, H.C.; Agri, M. The life cycle, pathology and taxonomy of two different nut rot fungi in chestnut. Aust. Nutgrow. 2008, 22, 11–15. [Google Scholar]
- Smith, H.C.; Ogilvyi, D. Nut rot in chestnuts. Aust. Nutgrow. 2008, 2, 10–15. [Google Scholar]
- Shuttleworth, L.A.; Liew, E.C.Y.; Guest, D.I. Survey of the incidence of chestnut rot in south-eastern Australia. Aust. Plant Pathol. 2012, 42, 63–72. [Google Scholar] [CrossRef]
- Çakar, D.; Şimşek, S.A. First report of Gnomoniopsis smithogilvyi causing nut rot on Castanea sativa in Turkey. New Dis. Rep. 2022, 46, e12105. [Google Scholar] [CrossRef]
- Chandelier, A.; Massot, M.; Fabreguettes, O.; Gischer, F.; Teng, F.; Robin, C. Early detection of Cryphonectria parasitica by real-time PCR. Eur. J. Plant Pathol. 2018, 153, 29–46. [Google Scholar] [CrossRef]
- Ivić, D.; Novak, A. Fungi associated with nut rot in sweet chestnut, with the first record of Gnomoniopsis smithogilvyi in Croatia. Pomologia Croatica 2018, 22, 13–22. [Google Scholar] [CrossRef]
- Gentile, S.; Valentino, D.; Visentin, I.; Tamietti, G. Discula pascoe infections of sweet chestnut fruits in North-West Italy. Aust. Nutgrow. 2009, 23, 23–25. [Google Scholar]
- Magro, P.; Speranza, S.; Stacchiotti, M.; Martignoni, D.; Paparatti, B. Gnomoniopsis associated with necrosis of leaves and chestnut galls induced by Dryocosmus kuriphilus. Plant Pathol. 2010, 59, 1171. [Google Scholar] [CrossRef]
- Vinale, F.; Ruocco, M.; Manganiello, G.; Guerrieri, E.; Bernardo, U.; Mazzei, P.; Piccolo, A.; Sannino, F.; Caira, S.; Woo, S.L.; et al. Metabolites produced by Gnomoniopsis castanea associated with necrosis of chestnut galls. Chem. Biol. Technol. Agric. 2014, 1, 294. [Google Scholar] [CrossRef]
- Lione, G.; Gonthier, P. A permutation-randomization approach to test the special distribution of plant diseases. Phytopathology 2016, 106, 19–28. [Google Scholar] [CrossRef] [PubMed]
- Ruocco, M.; Lanzuise, S.; Lombardi, N.; Varlese, R.; Aliberti, A.; Carpenito, S.; Woo, S.L.; Scala, F.; Lorito, M. New tools to improve the shelf life of chestnut fruit during storage. Acta Hortic. 2016, 1144, 309–316. [Google Scholar] [CrossRef]
- Seddaiu, S.; Cerboneschi, A.; Sechi, C.; Mello, A. Gnomoniopsis castaneae associated with Dryocosmus kuriphilus galls in chestnut stands in Sardinia (Italy). iForest 2017, 10, 440–445. [Google Scholar] [CrossRef]
- Vannini, A.; Morales-Rodriguez, C.; Aleandri, M.; Bruni, N.; Dalla Valle, M.; Mazzetto, T.; Martignoni, D.; Vettraino, A. Emerging new crown symptoms on Castanea sativa (Mill.): Attempting to model interactions among pests and fungal pathogens. Fungal Biol. 2018, 122, 911–917. [Google Scholar] [CrossRef]
- Vettraino, A.M.; Bianchini, L.; Caradonna, V.; Forniti, R.; Goffi, V.; Zambelli, M.; Testa, A.; Vinciguerra, V.; Botondi, R. Ozone gas as a storage treatment to control Gnomoniopsis castanea, preserving chestnut quality. J. Sci. Food Agric. 2019, 99, 6060–6065. [Google Scholar] [CrossRef]
- Driss, J.O. Chestnut Rots: Disease Incidence and Molecular Identification of Causal Agents. Master’s Thesis, Biotechnological Engineering, Instituto Politécnico de Bragança, Bragança, Portugal, 2019; p. 44. Available online: https://bibliotecadigital.ipb.pt/bitstream/10198/20487/1/pauta-relatorio-17.pdf (accessed on 20 March 2021).
- Meyer, J.B.; Gallien, L.; Prospero, S. Interaction between two invasive organisms on the European chestnut: Does the chestnut blight fungus benefit from the presence of the gall wasp? FEMS Microbiol. Ecol. 2015, 91, fiv122. [Google Scholar] [CrossRef][Green Version]
- EPPO—European and Mediterranean Plant Protection Organization Data sheets on quarantine pests—Dryocosmus kuriphilus. EPPO Bull. 2005, 35, 422–424.
- EFSA Risk assessment of the oriental chestnut gall wasps Dryocosmus kuriphilus for the EU territory and identification and evaluation of risk management options. EFSA J. 2010, 8, 114.
- Fernández, M.M.; Bezos, D.; Diez, J.J. Fungi associated with necrotic galls of Dryocosmus kuriphilus (Hymenoptera: Cynipidae) in northern Spain. Silva Fenn. 2018, 52, 9905. [Google Scholar] [CrossRef]
- Pasche, S.; Crovadore, J.; Pelleteret, P.; Jermini, M.; Mauch-Mani, B.; Oszako, T.; Lefort, F. Biological control of the latent pathogen Gnomoniopsis smithogylvyi in European chestnut grafting scions using Bacillus amyloliquefaciens and Trichoderma atroviride. Dendrobiology 2016, 75, 113–122. [Google Scholar] [CrossRef]
- Silva-Campos, M.; Callahan, D.L.; Cahill, D.M. Metabolites derived from fungi and bacteria suppress in vitro growth of Gnomoniopsis smithogilvyi, a major threat to the global chestnut. Metabolomics 2022, 18, 74. [Google Scholar] [CrossRef] [PubMed]
- Bastianelli, G.; Morales-Rodríguez, C.; Caccia, R.; Turco, S.; Rossini, L.; Mazzaglia, A.; Thomidis, T.; Vannini, A. Use of Phosphonate Salts to Control Chestnut ‘Brown Rot’ by Gnomoniopsis castaneae in Fruit Orchards of Castanea sativa. Agronomy 2022, 12, 2434. [Google Scholar] [CrossRef]
- Silva-Campos, M.; Islam, M.T.; Cahill, D.M. Fungicide control of Gnomoniopsis smithogilvyi, causal agent of chestnut rot in Australia. Australas. Plant Pathol. 2022, 51, 483–494. [Google Scholar] [CrossRef]
- Donis-González, I.R.; Fulbright, D.W.; Ryser, E.T.; Guyer, D. Efficacy of postharvest treatments for reduction of molds and decay in fresh Michigan chestnuts. Acta Hortic. 2010, 866, 563–570. [Google Scholar] [CrossRef]
- Donis-González, I.R.; Jeong, S.; Guyer, D.E.; Fulbright, D.W. Microbial contamination in peeled chestnuts and the efficacy of postprocessing treatments for microbial spoilage management. J. Food Process. Preserv. 2017, 41, e12874. [Google Scholar] [CrossRef]
- Regulamento (EU) 2019/1009 do Parlamento Europeu e do Conselho de 05 de Junho de 2019 que estabelece regras relativas à disponibilização no mercado de produtos fertilizantes EU e que altera os Regulamentos (CE) n.º 1069/2009 e (CE) n.º 1107/2009 e revoga o Regulamento (CE) n.º 2003/2003. J. Off. Da União Eur. 2019, 170, 1–114.
- Toolkiattiwong, P.; Arunrat, N.; Sereenonchai, S. Environmental, Human and Ecotoxicological Impacts of Different Rice Cultivation Systems in Northern Thailand. Int. J. Environ. Res. Public Health 2023, 20, 2738. [Google Scholar] [CrossRef]
- Huang, J.; Xu, C.; Ridoutt, B.G.; Chen, F. Reducing agricultural water footprints at the farm scale: A case study in the Beijing region. Water 2015, 7, 7066–7077. [Google Scholar] [CrossRef]
- Morales-Rodriguez, C.; Bastianelli, G.; Caccia, R.; Bedini, G.; Massantini, R.; Moscetti, R.; Thomidis, T.; Vanninia, A. Impact of ‘brown rot’ caused by Gnomoniopsis castanea on chestnut fruits during the postharvest process: Critical phases and proposed solutions. J. Sci. Food Agric. 2022, 102, 680–687. [Google Scholar] [CrossRef] [PubMed]
- de Agricultura e Veterinária, D.G. (Ed.) DGAV Manual de Procedimentos—Exportação de Castanha em Fresco Submetida a Tratamento Com água Quente em Sistema Contínuo—Procedimento a Adotar nas Centrais de Armazenagem e Embalagem (CAE) de Castanha; Direção Geral de Agricultura e Veterinária: Lisbon, Portugal, 2018. [Google Scholar]

| Diagnostic Method | Target Gene/Morphological Features | Method Sensitivity | Chestnut Tissues Where the Method Was Applied | Reference |
|---|---|---|---|---|
| Morphological-based | ||||
| Colonies in Potato Dextrose Agar medium | Creamy white or light brown with diffused to regular margins, and slimy conidial creamy mass drops on the surface. Woolly to felty mycelium with development in concentric circles. | Symptomatic or asymptomatic burrs and nuts | [23,46] | |
| Cankered bark | [26] | |||
| Conidiomata | Brownish to black, 200 × 158 µm | In fungal cultures | [42] | |
| Conidia | Hyaline, oval, obovoid, fusoid and multigutulate, and 5.07 to 9.01 × 1.9 to 4.38 µm in size. | In fungal cultures | [23,46] | |
| Molecular-based | ||||
| PCR | Internal transcribed spacers (ITS) region (ITS1-5.8S-ITS2) | Mycelium * | [20,23,26,42,46,47,48] | |
| PCR | ITS region (168 bp) with specific primers developed for G. smithogilvyi | Mycelium * | [38] | |
| PCR | Large subunit (LSU) | Mycelium * | [48] | |
| PCR | Translation elongation factor 1-alpha (TEF1-α) | Mycelium * | [23,42,46,47,48] | |
| PCR | Beta-tubulin (β-tubulin) | Mycelium * | [46,47,48] | |
| PCR | Calmodulin | Mycelium * | [47] | |
| PCR | RNA polymerase II (RPB2-1 and RPB2-2) | Mycelium * | [48] | |
| Multiplex PCR | ITS, TEF1-α, β-tubulin | 5–50 fg/μL | Chestnut fruit | [49] |
| Real-time PCR | TEF1-α | 40 fg of pure fungal DNA | Chestnut fruit, leaves and twigs | [45] |
| TEF1-α | 0.128 pg/μL | Chestnut fruit | [50] | |
| High-Throughput Sequencing | ITS1 | Chestnut fruit | [45] | |
| Visual-Loop-mediated isothermal amplification (V-LAMP) | TEF1-α | 0.64 pg/μL | Chestnut fruit | [50] |
| Portable real-time LAMP (P-LAMP) | TEF1-α | 0.128 pg/μL | Chestnut fruit | [50] |
| Continent | Country | Host | Observed Symptoms/Asymptomatic | Incidence of the Disease (%) | Reference |
|---|---|---|---|---|---|
| AMERICA | Chile | C. sativa | Asymptomatic fruits | 3.7–6.5 | [8] |
| USA | C. mollissima C. sativa × C. crenata | Fruit rot | [52] | ||
| ASIA | Australia & New Zealand | C. sativa C. sativa × C. crenata | Fruit rot | [53] | |
| Australia | Castanea spp. | Fruit rot | [54] | ||
| Castanea spp. | Fruit rot; asymptomatic in dead burrs | [55] | |||
| C. sativa C. crenata × C. sativa | Fruit rot; asymptomatic in the other parts of the tree, such as female flowers, male flowers, pedicels, petioles of terminal leaves, and bark | [37] | |||
| C. sativa | Fruits | 46 | [49] | ||
| India | C. sativa | Canker in shoots, stems, and branches | 33–58 | [26] | |
| Turkey 1 | C. sativa | Fruit | 19 | [56] | |
| EUROPE | Belgium | C. sativa | Bark canker | [57] | |
| Croatia | C. sativa × C. crenata | Fruits | 75 | [58] | |
| France, Italy & Switzerland | C. sativa | Fruit rot; asymptomatic in bark and floral shoots (artificial inoculation) | 80 | [21] | |
| France, Italy & Switzerland | C. sativa | Fruit rot | [36] | ||
| France and Italy | C. sativa | Fruit rot | [38] | ||
| Ireland | C. sativa | Canker in branches | [29] | ||
| Italy | C. sativa | Fruit rot; asymptomatic in other parts of the plant (e.g., pistils and flowers, developing fruits, and external tissues of the burr) | [59] | ||
| Castanea spp. | Necrosis in leaves and galls of D. kuriphilus, blight symptoms in the branches (artificial inoculation) | [60] | |||
| C. sativa | Fruit rot; asymptomatic in bark and young shoots | 8–49/2–24 2 | [42] | ||
| Castanea spp. | Not specified in the galls of D. kuriphilus | [61] | |||
| C. sativa | Asymptomatic in shoots and galls of D. kuriphilus | [44] | |||
| C. sativa | Fruit rot | [62] | |||
| C. sativa | Fruit rot; asymptomatic in ripe fruits; non-specific in the galls of D. kuriphilus | [63] | |||
| C. sativa | Necrosis in galls of D. kuriphilus; asymptomatic in leaves | [24,25] | |||
| C. sativa | Necrosis or asymptomatic in galls of D. kuriphilus | 68 | [64] | ||
| C. sativa | Fruit rot; necrosis in the galls of D. kuriphilus; asymptomatic in bark, shoots, leaves, galls of D. kuriphilus, and fruits | 80 | [43,65] | ||
| C. sativa | Fruit rot; asymptomatic fruits | [50] | |||
| C. sativa | Ripe fruits | 20–93 | [38] | ||
| C. sativa | Fruits | 19 | [66] | ||
| C. sativa | Bulk fruit samples | 0.17–64.11 | [45] | ||
| Portugal | C. sativa | Fruit rot | 6.4 | [67] | |
| C. sativa | Fruit rot | 8.0/5.3/5.0 3 | [20] | ||
| United Kingdom | C. sativa | Canker in the shoots | [27] | ||
| Slovenia | C. sativa C. crenata × C. sativa | Fruit rot; canker in branches | [32] | ||
| Spain | C. sativa | Nuts and burrs | [46] | ||
| C. sativa × C. crenata | Canker in branches | [28] | |||
| Switzerland | C. sativa | Fruit rot; asymptomatic in ripe fruits | 91 | [47] | |
| C. sativa | Unspecified in abandoned necrotic galls of D. kuriphilus | 54 | [68] | ||
| C. sativa | Canker in galls and shoots; asymptomatic in shoots, wood, bark, and leaves, as well as at the vascular level | [31] | |||
| C. sativa | Abandoned D. kuriphilus galls and wood bark cankers | 54 | [48] |
| Stage | Method | Reference |
|---|---|---|
| Pre-harvest | Preventive
| [18] |
| Control | ||
| - Use of antagonists, such as Bacillus amyloliquefaciens and Trichoderma atroviride | [72,73] | |
| - Use of fertilizers, such as Kalex Zn product (Alba Milagro®), and application of Mystic® 430 SC (Nufarm Italia Ltd., Milano, Italy, at 40.18% (w/v) of tebuconazole. This product is used as conventional chemical treatment against fungal contamination) | [74] | |
| - Use of fungicides 1: pyraclostrobin; prochloraz; iprodione; fludioxonil; difenoconazole; cyprodinil + fludioxonil; pyraclostrobin + difenoconazole | [75] | |
| Post-harvest | - Disinfectants 2: hydrogen peroxide + peracetic acid; trifloxystrobin; hydrogen peroxide + peracetic acid + caprylic acid + glycolic acid + capric acid; fludioxonil; caprylic acid + glycolic acid + capric acid; chlorine dioxide; sodium metabisulfite; sodium hypochlorite; aluminum hydroxide acetate; copper sulphate; aqueous ozone; peracetic acid. | [76] |
| - Post-processing treatments applied to inoculated peeled chestnuts 3: X-ray irradiation (70 kV/57 mA, doses 0.5, 1, 1.5, 2 kGy); StorOx (2700 ppm hydrogen dioxide + 200 ppm peracetic acid); Agri-cide (1 ppm); 10 ppm chlorine dioxide solution; 0.70 ppm ozone solution; 80 ppm peracetic acid; 100 ppm chlorine solution; 0.2 M sodium chloride; warm water at 65 °C) | [77] | |
| - Gaseous ozone | [66] | |
| - Hot-water treatment + enzymes able to degrade the fungal cell wall | [63] |
Disclaimer/Publisher’s Note: The statements, opinions and data contained in all publications are solely those of the individual author(s) and contributor(s) and not of MDPI and/or the editor(s). MDPI and/or the editor(s) disclaim responsibility for any injury to people or property resulting from any ideas, methods, instructions or products referred to in the content. |
© 2023 by the authors. Licensee MDPI, Basel, Switzerland. This article is an open access article distributed under the terms and conditions of the Creative Commons Attribution (CC BY) license (https://creativecommons.org/licenses/by/4.0/).
Share and Cite
Lema, F.; Baptista, P.; Oliveira, C.; Ramalhosa, E. Brown Rot Caused by Gnomoniopsis smithogilvyi (syn. Gnomoniopsis castaneae) at the Level of the Chestnut Tree (Castanea sativa Mill.). Appl. Sci. 2023, 13, 3969. https://doi.org/10.3390/app13063969
Lema F, Baptista P, Oliveira C, Ramalhosa E. Brown Rot Caused by Gnomoniopsis smithogilvyi (syn. Gnomoniopsis castaneae) at the Level of the Chestnut Tree (Castanea sativa Mill.). Applied Sciences. 2023; 13(6):3969. https://doi.org/10.3390/app13063969
Chicago/Turabian StyleLema, Filipe, Paula Baptista, Cristina Oliveira, and Elsa Ramalhosa. 2023. "Brown Rot Caused by Gnomoniopsis smithogilvyi (syn. Gnomoniopsis castaneae) at the Level of the Chestnut Tree (Castanea sativa Mill.)" Applied Sciences 13, no. 6: 3969. https://doi.org/10.3390/app13063969
APA StyleLema, F., Baptista, P., Oliveira, C., & Ramalhosa, E. (2023). Brown Rot Caused by Gnomoniopsis smithogilvyi (syn. Gnomoniopsis castaneae) at the Level of the Chestnut Tree (Castanea sativa Mill.). Applied Sciences, 13(6), 3969. https://doi.org/10.3390/app13063969









